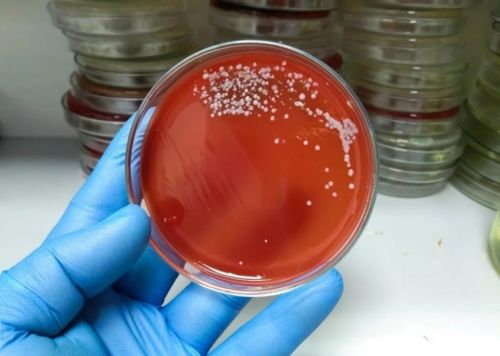

«М’ясоїдна бактерія»: світом шириться смертельна хвороба
Рідкісна бактерія зафіксована в Японії (а також в країнах ЄС), вона здатна вбити людину за 48 годин.
У першій половині 2024 року в Японії, особливо у Токіо, зареєстровано безпрецедентна кількість випадків смертельно небезпечного синдрому токсичного шоку. Це рідкісне захворювання, що вбиває людину протягом 48 годин.
Синдром стрептококового токсичного шоку (STSS) спричинив велике занепокоєння серед лікарів та громадськості. Лише у Токіо таких випадків – 145.
«М’ясоїдна бактерія» небезпечна тим, що у 30% випадків вбиває людину, причому більшість заражень – це люди старше 30 років. Також у тих, хто виживе, існує висока ймовірність втрати кінцівок через некроз тканин.
Що таке синдром стрептококового токсичного шоку?
Японські вчені зазначають, що збудник хвороби – це стрептокок А iGAS. Бактерія передається повітряно-краплинним шляхом і при побутовому контакті з хворою людиною (відрізняється високою заразністю). Зазвичай зараження починається з горла, хоча інфекція може початися і з шкіри.
Вперше про смертельну хворобу в Японії почали говорити ще у 2017 році, проте тоді було зафіксовано лише кілька десятків випадків.
Кен Кікучі, професор-інфекціоніст Токійського медичного університету, посилаючись на дослідження, наголошує, що станом на червень є вже 977 випадків STSS. А це – більше, ніж за увесь 2023 рік.

Симптоми стрептококового токсичного шоку
Серед симптомів STSS – такі:
- біль та набряк у горлі, як при ангіні;
- набряки і біль у ногах;
- лихоманка;
- зниження артеріального тиску;
- некроз сполучних тканин, що швидко прогресує.
У зоні ризику люди з ослабленим імунітетом, а також ті, хто страждає на хронічну втому. Ризики заразитися також вищі у тих, хто хворіє на ГРЗ.
Токсичний шок відбувається через здатність стрептококової бактерії проникати глибоко в організм (кров і органи, що знаходяться всередині тіла). Все це викликає відмову органів.
Хвороба "Х": що це і чи варто панікувати?
«Більшість смертей відбувається протягом 48 годин. Як тільки пацієнт помічає набряк на стопі вранці, до обіду цей набряк може поширитися на коліно. І людина може померти протягом 48 годин», – розповів Кен Кікучі.
Якщо темпи зараження STSS будуть зберігатися такими самими, як зараз, кількість заражених цього року може сягнути 2500 (біля 30% з них помруть).
Також про випадки нетипового шокового синдрому у 2022 році почали повідомляти у ВООЗ вчені з європейських країн (тоді таких країн було п’ять). У ВООЗ пояснюють, що поширення «м’ясоїдної бактерії» сталося після зняття ковідних обмежень.
Лише протягом перших 10 тижнів 2024 року було зареєстровано 474 зараження STSS. Офіційні представники охорони здоров’я закликають дотримуватися правил особистої гігієни, часто мити руки, не переносити вірусні інфекції на ногах та не залишати без уваги будь-які рани на тілі, адже стрептокок часто проникає в організм саме через них. Як тільки з’являються тривожні симптоми, терміново потрібно звернутися до лікаря, щоб зменшити вірогідність ускладнень.
















 Medcentre.com.ua Медичний інформаційний ресурс
Medcentre.com.ua Медичний інформаційний ресурс 


Коментарі